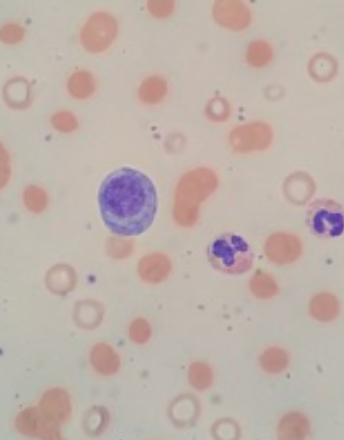

Loading
Archive
Recommended Articles
T cell engagers targeting CD19 to treat B cell malignancies, and beyond
In the past decade, a tremendous progress has been made in developing T cell engaging bi-specific antibodies (BsAbs) targeting CD19 to treat B cell malignancies. The T cell engaging bi-specific molecule binds to CD3 on a T cell and a tumor-associated antigen (TAA) on a target cell and redirects the T cell to a specific target cell bypassing the MHC restriction mechanism, leading to the formation of immune synapse between the T cell and target cell and target cell lysis.
Recent advancements to characterize human blood via thixo-visco-elasto-plastic modeling
In the previous several years there has been much progress in developing more accurate thixo- lasto- visco-plastic rheological models that can be used to mechanically characterize human blood. In theory as the thixo-elasto-visco-plastic (TEVP) model accuracy and predictive capability improves, the parameterization, as well as insights and parametric correlations will also improve.
Prevalence of anemia and associated factors among Under-five children attended at Bule Hora general hospital, West Guji zone, Oromia region, Southern Ethiopia
Anemia is a condition that causes decline of erythrocytes concentration in circulation or hemoglobin in the blood and a concomitant impairment of oxygen transportation. The World Health Organization (WHO) defined as hemoglobin (Hgb)<12 g/dL in adult non-pregnant women, Hgb <11g/dL in pregnant females, Hgb <13g/dL in adult men, Hgb <11g/dl in children whose age is 6-59 months, Hgb <11.5 g/dl in children whose age is 5-11years, Hgb<12 g/dl for children whose age is 12-14 years and Hgb <13 g/dL in newborns.
Primary CNS lymphoma (PCNSL) - Introducing to hippocampal dose-reduction whole brain radiotherapy (HDR-WBRT)
Primary central nervous system lymphoma (PCNSL) is a rare and aggressive extranodal Non Hodgkin Lymphoma. Combined modality treatment with high-dose methotrexate (HD-MTX) followed by whole brain radiotherapy (WBRT) has been a commonly used treatment approach.
Activated phosphoinositide-3-kinase delta syndrome presenting with early onset (infantile) autoimmune thrombocytopenia
Activated phosphoinositide 3-kinase delta syndrome (APDS) is a rare syndrome of immune dysregulation that is inherited in an autosomal dominant fashion and results in varying severity of the clinical phenotype. APDS is a result of a gain-of-function mutation in the gene PIK3CD, which codes for a catalytic subunit of the PI3K-Delta kinase.
A novel multiparameter comprehensive hemostasis assessment biosensor
Rapid, accurate, and comprehensive assessment of hemostasis is of great importance in many clinical settings. Key hematological indices routinely assessed in bleeding patients or patients at risk for bleeding are coagulation function, platelets, and hematocrit. Current clotting assays are limited to a partial analysis of hemostasis (individual faceted clotting elements), thereby providing an incomplete assessment of bleeding and thrombotic risks and status.
Warts, hypogammaglobulinemia, infections, and myelokathexis (WHIM) syndrome and tetralogy of fallot; Case report and literature review
WHIM (Warts, Hypogammaglobulinemia, Infections, and Myelokathexis) syndrome is a rare primary immunodeficiency disorder characterized by susceptibility to human papillomavirus (HPV) infections, neutropenia, and hypogammaglobulinemia.
Research progress and prospect of circular RNA in multiple myeloma
Multiple myeloma (MM) is a clonal plasma cell neoplasm manifested by anemia, hypercalcemia, impairment of renal function and bone destruction. It is now the second most common malignancy in hematology.
Efbemalenograstim alfa, a long-acting granulocyte colony-stimulating factor, a novel dimeric G-CSF Fc fusion protein for reducing the risk of febrile neutropenia following chemotherapy
Chemotherapy?induced neutropenia (CIN) can cause life-threatening complications such as febrile neutropenia (FN) or other infections. Patients who develop FN often require prolonged hospitalizations and treatment with broad-spectrum antibiotics.
Taking BAFF-R targeting CAR T-cells on the road
Chimeric antigen receptor (CAR) T cells were first clinically tested in trials against metastatic solid tumors without therapeutic benefit; however, these efforts established the necessary domains that are required for a functional CAR T-cell. With the characterization of cells within the immune system, the expression of CD19 was found to dictate B cell lineage that remains present on normal and malignant B cells.
Commentary: Three-dimensional transvaginal ultrasound diagnosis of interstitial ectopic pregnancy in a unicornuate uterus: A case report
Unicornuate uterus represents a congenital uterine anomaly, with an incidence of approximately 0.1%-0.4%. The discourse surrounding the administration of interstitial pregnancy persists as a subject of contention. This uncommon malady is on the rise in terms of frequency, encompassing approximately 2%-6.8% of all instances of ectopic gestations and comprising 2%-4% of tubal ectopic pregnancies.
Commentary on “Ultrasmall polyvinylpyrrolidone-modified iridium nanoparticles with antioxidant and anti-inflammatory activity for acute pancreatitis alleviation”
Acute pancreatitis (AP) can lead to severe body damage, including a systemic inflammatory response and multiorgan failure, and current therapies rely heavily on symptomatic treatment and supportive care, with a lack of targeted therapeutic strategies for specific pathologic processes.
Gender disparity in the reticulocyte count of HIV-positive patients on HAART management in Ilorin
Reticulocytes are immature red blood cells (RBCs). In the process of erythropoiesis (red blood cell formation), reticulocytes develop and mature in the bone marrow and then circulate for about a day in the bloodstream before developing into mature red blood cells.
The tip of the reproductive screening iceberg: ‘Every mother and every fetus matters’
The basic maternity preventive, diagnostic, and treatment services support for the ‘beginning of life’ are routinely offered, as outlined in the ‘Every Mother and Every Fetus Matters’ manuscript. The routine maternity screening tests are important and necessary but if the fetal screening or imaging procedures identifies fetal pathology, the routine maternal screening tests are only the tip of the screening and diagnostic iceberg.
An overview of clinical, molecular, and therapeutic approaches to Niemann-Pick disease
In animal cells (especially humans), there is an enzyme called acid sphingomyelinase (ASM) (EC 3.1.4.12) which can break the large molecule of sphingomyelin and convert it into smaller structures of ceramide and phosphorylcholine.
How effective are antioxidants without fetal hemoglobin in tackling oxidative stress in sickle cell disease?
Sickle cell disorder (SCD) remains a disease of public interest, accounting for a significant number of deaths, especially in low and middle-income countries in Africa. Despite years of intensive studies, its cure remains a subject of ongoing investigation.
Acquired cutis laxa: Hematological insights and therapeutic implications in a paraneoplastic context
Acquired cutis laxa (ACL) is a rare dermatological disorder characterized by loose, sagging, and inelastic skin due to the progressive degradation of elastic fibers within the dermis. Unlike the congenital form of cutis laxa, which is present from birth and often linked to genetic mutations, ACL typically develops later in life and can be associated with various underlying conditions.
Commentary on “Beyond infantile hemangiomas: A glimpse into overlapping rare syndromes emphasizing the vigilant screening for PHACE and LUMBAR syndromes”
Due to their complex etiology and pathogenesis, hemangioma-related syndromes, such as LUMBAR and PHACE, present diagnostic and therapeutic challenges. Despite advances, standardized diagnostic criteria, screening protocols, and treatment options still need to be developed. We report a rare case of a 1-month-old patient with nonspecific symptoms, including failure to thrive and poor feeding, associated with lumbosacral ulcers.
Artificial intelligence in hematology: A critical perspective
The increasing prevalence of drug-resistant pathogens has highlighted the need for innovative approaches in drug discovery, including drug re-purposing. Artificial intelligence (AI) has emerged as a transformative tool in this endeavor, with the potential to revolutionize not only drug re-purposing for infectious diseases but also the field of hematology.
Cardiac toxicities of Bruton's tyrosine kinase inhibitors: The risk of pericarditis and cardiac tamponade
Nearly a decade since the introduction of first-generation Bruton’s tyrosine kinase (BTK) inhibitors in the treatment of chronic lymphocytic leukaemia (CLL), their use has expanded with the second-generation agents zanubrutinib and acalabrutinib. These agents show high efficacy particularly in patients with TP53 mutations or del(17p).